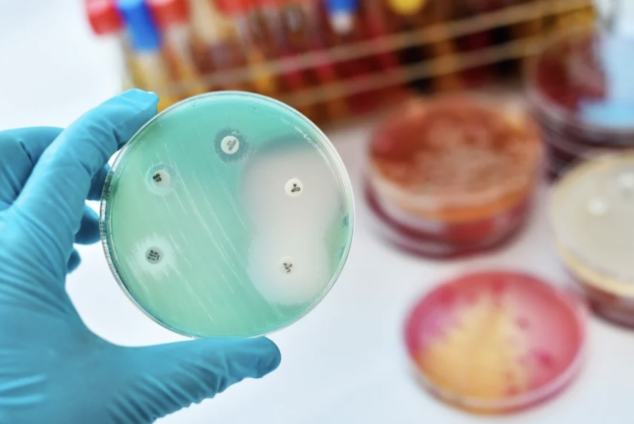

Audio By Carbonatix
Staphylococcus aureus is the source of a skin infection that can turn deadly if drug resistant. Estimates regarding the most common resistant variation, methicillin-resistant Staphylococcus aureus (MRSA), exceed 100,000 deaths globally in 2019.
But up until recently, we did not have a solid grasp on how much of a problem MRSA - or any other antimicrobial-resistant pathogen - was in Africa. It turns out, after testing 187,000 samples from 14 countries for antibiotic resistance, our colleagues found that 40% of all Staph infections were MRSA.
Africa, like every other continent, has an AMR problem. But Africa stands out because we have not invested in the capacity and resources needed to determine the scope of the problem, or how to fix it. Take MRSA. We still don’t know what’s causing the bacteria to become resistant, nor do we know the full extent of the problem.
We are failing to take AMR seriously, perhaps because it is not glamorous and relatable. The technology that we currently use to identify resistant pathogens is not fancy or futuristic looking. Combatting AMR does not involve miracle drugs, expensive treatments, or fancy diagnostic tests. Instead, we have bacteria and other pathogens that are commonplace and have learned how to shrug off the good old medicines that used to work.
The global health and pharmaceutical industries do not seem to consider solving this problem to be very profitable. Compare that to the urgency of solving COVID-19, which has been embraced—and interventions such as diagnostics subsidized—by governments eager to end the pandemic. The COVID-19 response has been characterized by innovations popping up literally every other week.
Why can’t we mobilize resources and passion for AMR? Are resistant pathogens too boring? Is it too difficult to solve through innovations? Does this make prospects for quick wins and fast return on investment too elusive for AMR, especially when compared to COVID-19 or other infectious disease outbreaks?
The World Health Organization (WHO) has repeatedly stated that AMR is a global health priority—and is in fact one of the leading public health threats of the 21st century. A recent study estimated that in 2019, nearly 1.3 million people died because of antimicrobial-resistant bacterial infections, with Africa bearing the greatest burden of deaths. A high prevalence of AMR has also been identified in foodborne pathogens isolated from animals and animal products in Africa.
Collectively, these numbers suggest that the burden of AMR might be on the level of—or greater than—that of HIV/AIDS or COVID-19. The growing threat of AMR is likely to take a heavy toll on Africa’s health systems and poses a major threat to progress made in attaining public health goals set by individual nations, the African Union and the United Nations. And the paucity of accurate AMR information limits our ability to understand how well commonly used antimicrobials actually work. This also means we cannot determine the drivers of AMR infections and design effective interventions in response.
We have just wrapped up a project that gathered data on many of the scariest pathogens in 14 countries, revealing stark insights into the under-detected and under-reported depth of the AMR crisis across Africa. Less than two per cent of the medical laboratories in the 14 countries examined can conduct bacteriology testing, even with conventional methods that were developed more than 30 years ago.
While providing national stakeholders with critical information to advance their policies on AMR, we have also trained and provided basic electronic tools to more than 300 health professionals to continue this important surveillance. While a strengthened workforce is critical, many health facilities on the continent are coping with interrupted access to electricity, poor connectivity, and serious, ongoing workforce shortages.
Our work has painted the dire reality of the AMR surveillance situation, informing concrete recommendations for improvement that align with the new continental public health ambition of the African Union and Africa Center for Disease Control (CDC). The challenge is to find the funding to expand this initiative to cover the entire African continent.
AMR containment requires a long-term focus—especially in Africa, where health systems are chronically underfunded, while also being disproportionately challenged by infectious threats. More funding needs to be dedicated to the problem and this cannot only come from international aid.
We urge African governments to honour past commitments and allocate more domestic funding to their health systems in general, and to solving the crisis of AMR in particular. We also call upon bilateral funders and global stakeholders to focus their priorities on improving the health of African peoples.
This might require more attention to locally relevant evidence to inform investments and less attention to profit-driven market interventions, as well as prioritizing the scale-up of technologies and strategies proven to work, whether or not they are innovations.
Containing AMR means we have to fix African health systems. The work starts now.
****
Dr Pascale Ondoa is the director of science and new initiatives of the African Society for Laboratory Medicine (ASLM) and Dr Yewande Alimi is the Africa Center for Disease Control (CDC) antimicrobial resistance programme coordinator.
Latest Stories
-
Prosecution witness alleges Chairman Wontumi ordered mining in protected Tano Nimiri Forest Reserve
37 minutes -
31 people dead after bus crashes in Ethiopia
38 minutes -
G7 leaders meet in France with Iran and Ukraine high on agenda
45 minutes -
South Africa marks 50 years since Soweto uprising amid modern youth crisis
49 minutes -
Engineer calls for greater citizen responsibility in tackling Ghana’s flood crisis
54 minutes -
GRA targets informal sector with modified tax scheme
55 minutes -
Embed climate education in national climate policies—AGN Chair
1 hour -
Eight dead after US Air Force B-52 bomber crashes in California
1 hour -
Ken Ofori-Atta’s lawyers claim US immigration court has approved his Green Card application
1 hour -
Ghana records weakest Q1 budget execution since 2017 as consolidation bites
1 hour -
NPP accuses government of selective justice, warns against interference in Sedina Tamakloe’s sentence
1 hour -
Ashaiman Police arrest two suspects over separate armed robbery attacks
1 hour -
Port charges hindering access to donated medicines, cancer charity warns
2 hours -
See the areas that will be affected by ECG’s planned maintenance on Tuesday
2 hours -
Mahama’s lean government claim misleading when full appointments are considered – Jinapor
2 hours